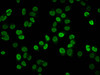
Immunofluorescence staining of Hela cells (treated with 10mM sodium propionate for 4h) with CSB-PA010429OA08propHU at 1:25, counter-stained with DAPI. The cells were fixed in 4% formaldehyde, permeabilized using 0.2% Triton X-100 and blocked in 10% normal Goat Serum. The cells were then incubated with the antibody overnight at 4°C. The secondary antibody was Alexa Fluor 488-congugated AffiniPure Goat Anti-Rabbit IgG (H+L) .

Cusabio Polyclonal Antibodies
Propionyl-HIST1H4A (K8) Antibody | CSB-PA010429OA08propHU
- SKU:
- CSB-PA010429OA08propHU
- Availability:
- 3 to 7 Working Days
Description
Propionyl-HIST1H4A (K8) Antibody | CSB-PA010429OA08propHU | Cusabio
Propionyl-HIST1H4A (K8) Antibody is Available at Gentaur Genprice with the fastest delivery.
Online Order Payment is possible or send quotation to info@gentaur.com.
Product Type: Polyclonal Antibody
Target Names: HIST1H4A
Aliases: Histone H4, HIST1H4A; HIST1H4B; HIST1H4C; HIST1H4D; HIST1H4E; HIST1H4F; HIST1H4H; HIST1H4I; HIST1H4J; HIST1H4K; HIST1H4L; HIST2H4A; HIST2H4B; HIST4H4, H4/A H4FA; H4/I H4FI; H4/G H4FG; H4/B H4FB; H4/J H4FJ; H4/C H4FC; H4/H H4FH; H4/M H4FM; H4/E H4FE; H4/D H4FD; H4/K H4FK; H4/N H4F2 H4FN HIST2H4; H4/O H4FO;
Background: Core component of nucleosome. Nucleosomes wrap and compact DNA into chromatin, limiting DNA accessibility to the cellular machineries which require DNA as a template. Histones thereby play a central role in transcription regulation, DNA repair, DNA replication and chromosomal stability. DNA accessibility is regulated via a complex set of post-translational modifications of histones, also called histone code, and nucleosome remodeling.
Isotype: IgG
Conjugate: Non-conjugated
Clonality: Polyclonal
Uniport ID: P62805
Host Species: Rabbit
Species Reactivity: Human
Immunogen: Peptide sequence around site of Propionyl-Lys (8) derived from Human Histone H4
Immunogen Species: Human
Applications: ELISA, WB, IF, IP, ChIP
Tested Applications: ELISA, WB, IF, IP, ChIP; Recommended dilution: WB:1:1000-1:5000, IF:1:20-1:200, IP:1:200-1:2000
Purification Method: Antigen Affinity Purified
Dilution Ratio1: ELISA:1:2000-1:10000
Dilution Ratio2: WB:1:1000-1:5000
Dilution Ratio3: IF:1:20-1:200
Dilution Ratio4: IP:1:200-1:2000
Dilution Ratio5:
Dilution Ratio6:
Buffer: Preservative: 0.03% Proclin 300
Constituents: 50% Glycerol, 0.01M PBS, pH 7.4
Form: Liquid
Storage: Upon receipt, store at -20°C or -80°C. Avoid repeated freeze.
Initial Research Areas: Epigenetics and Nuclear Signaling
Research Areas: Epigenetics & Nuclear Signaling